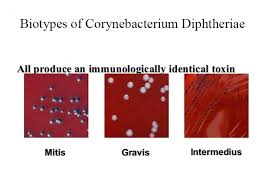

17 - Yersinia, Listeria, Erisypelothrix, Corynebacterium
1/18
There's no tags or description
Looks like no tags are added yet.
Name | Mastery | Learn | Test | Matching | Spaced |
|---|
No study sessions yet.
19 Terms
Kako izgleda Yersinia
Kakva je prema kisiku?
Je li patogen životinja ili ljudi?
Kakvi su testovi oksidaze i katalaze
Gram negativan štapić poput sigurnosne igle, ima jače bipolarno bojenje
Aerob je
Primarno je patogen životinja, a na ljude se prenosi dodirom sa životinjama ili konzumacijom životinjskim proizvoda
Katalaza i oksidaza +

Što uzrokuje Yersinia pestis i kako se prenosi?
Uzrokuje kugu, prenosi se ugrizom štakorske buhe
Simptomi: nakon ugriza buhe Yersinia je fagocitirana, ali se razmnožava unutar fagocita i ulazi u limfne čvorove. Limfni čvorovi nekrotiziraju i zovu se buboni
Širi se u krv, uzrokuje temp, sepsu, slabost, apscese u organima, kašljanje krvi, dispneja
Koji su uzorci i kako se diag?
Uzorak: aspirat LČ
Preparat po gramu, sadnja na KA
DFA za dokaz Ag
Kako izgleda Yersinia enterocolitica?
Kakva je prema kisiku?
Koja joj je optimalna temperatura?
Pri kojoj temp je pokretna?
Gram negativan kokobacil
Fakultativni anaerob
Optimalna temperatura joj je 25, raste na 37 i +4
Pokretna je pri 22-25
Kakve su kolonije na KA?
Kolonije su glatke, sjajne, uzdignute, bijelo krem boje

Kako se prenosi i što uzrokuje?
Prenosi se konzumacijom kontaminirane hrane i dodirom sa životinjama
Uzrokuje enterokolitis - proljev, povraćanje
Kako izgleda Listeria monocytogenes?
Kakva je prema kisiku?
Kakvi su joj testovi katalaze?
Na kojim temp raste i na kojoj temp je pokretna?
Gram pozitivan štapić pojedinačno ili u kraćim lancima
Fakultativni anaerob
Katalaza +
Raste na 35 i +4
Pokretna je na 22
Za što ima tropizam i kod koga je opasna?
Kako se prenosi?
Što uzrokuje?
Ima tropizam za SŽS i posteljicu, opasna je za trudnice i male bebe
Prenosi se transfuzijom, s majke na dijete, konzumacijom termički nedovoljno obrađene hrane
Uzrokuje
infekcije ploda (amnionitis, apscesi, smrt fetusa)
sepsu i meningitis
kod trudnice simptome slične gripi
proljev i povraćanje
Kako izgleda na KA?
Kolonije su 1 mm, glatke, sjajne, prozirne, uska zona beta hemolize

Na kojem agaru još raste?
Na Oxford i Palcam agaru

Kako izgleda Erysipelothrix rhusopatiae?
Kakav je prema kisiku?
Je li osjetljiva bakterija?
Gram pozitivan štapić pojedinačno, u kratkim lancima i dugim filamentima
Fakultativni je anaerob
Vrlo je otporan, preživljava visoke temp i soljenje
Kako dolazi do infekcije i što uzrokuje?
Kako se diag?
Do infekcije dolazi konzumacijom termički nedovoljno obrađenog mesa ili dodirom sa svinjom
Uzrokuje erizipeloid - limfadenitis i artritis šake
Uzorak je biopsija kože, radi se preparat po gramu, sadi se na KA i ČA. U stupcu želatine raste kao četka za pranje boca
Kako izgleda Corynebacterium diphtheriae?
Kako se boji po Loeffleru, a kako po Lubinskom?
Kakvi su testovi katalaze i oksidaze
Gram pozitivni štapići rasporeda poput kineskih slova, na kraju imaju zadebljanja (polimetafosfatna zrnca kao skladište E)
Po Loeffleru se štapić boji svijetloplavo, zrnca ljubičasto
Po Lubinskom štapić žutosmeđe, zrnca ljubičasto
Katalaza i oksidaza +

Koji je činitelj patogenosti?
Kako se prenosi i što uzrokuje?
Postoji li cjepivo?
Činitelj patogenosti je egzotoksin koji uzrokuje paralizu mišića
Prenosi se kapljično
Uzrokuje difteriju - temp, kašalj, upala grla, pseudomembranozne naslage na ždrijelu, paraliza dišnih mišića i začepljenje dišnih putova
Da, obavezno je cijepljenje djece!
Na kojem agaru raste?
Raste na KA, cistin telurit agaru i Tinsdale agaru?
Kako izgleda na KA?
Kolonije su 1 mm, okrugle, sivo bijele

Kako izgleda na cistin telurit agaru?
Postoje tipovi gravis, mitis, intermedius
Tip gravis - velike, sivo bijele, nazubljene, suhe i hrapave
Mitis - male, crne, sjajne, konveksne
Intermedius - male, crno središte, glatke i sjajne
Koji je uzorak i kako se diag?
Uzorak je bris ispod pseudomembrane ždrijela, bris NF
Radi se preparat po gramu
Dokaz polimetafosfatnih zrnaca
Sadnja na KA i cistin telurit
Dokaz toksina